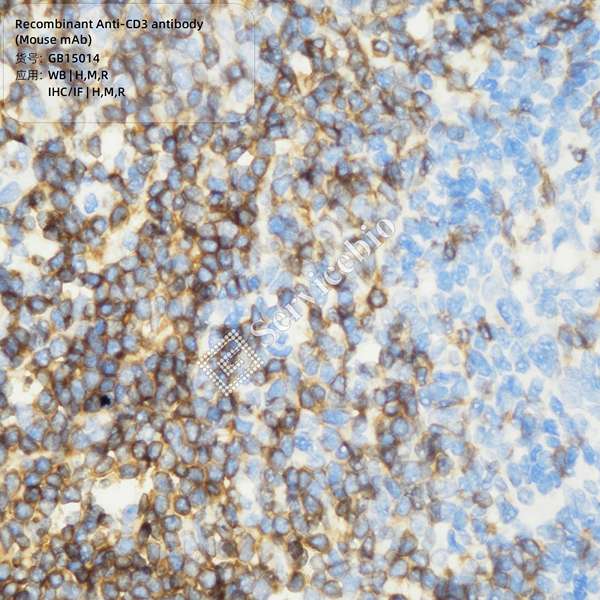
Антитела первичные, моноклональные, CD3, 100 мкл

Антитела первичные, моноклональные, CD3, 100 мкл
- Артикул:GB15014-100UL
- Производитель:Servicebio
- Наличие:Под заказ
Инструкции и сертификаты
- Производитель
Servicebio
- Тип антител
моноклональные
- Хозяин
мышь
- Вид антител
первичные
- Антиген
CD3
- Артикул
GB15014-100UL
- Метод
IHC/IF, WB
- Мишень
крыса, мышь, человек
- Фасовка
100 мкл
Характеристики
- Производитель
Servicebio
- Тип антител
моноклональные
- Хозяин
мышь
- Вид антител
первичные
- Антиген
CD3
- Артикул
GB15014-100UL
- Метод
IHC/IF, WB
- Мишень
крыса, мышь, человек
- Фасовка
100 мкл
Доставка и оплата
В компании «Молекулаб» условия транспортировки зависят от региона, типа продукции и температурного режима. Ниже приведена основная информация:
-
1. Регионы
Мы отправляем заказы по всей России. Уточните у менеджера детали для вашего местоположения. -
2. Варианты транспортировки
Доступны разные методы: курьерская служба, работа с транспортными компаниями или перевозка собственными силами. При оформлении заказа можно выбрать подходящий вариант с учетом габаритов и особенностей груза.
Примечание: Перевозчики доставляют товар до входа в здание или проходной. Если требуется занести груз на этаж, свяжитесь с менеджером для уточнения возможностей. -
3. Сроки
Время зависит от удаленности вашего региона и выбранного метода. Менеджер сообщит ориентировочные даты при оформлении. -
4. Стоимость
Для большинства товаров цена доставки рассчитывается автоматически на этапе добавления в корзину и оформления заказа. Если система не показала стоимость, значит, ваш товар имеет нестандартные габариты или требует специальных условий поставки – в этом случае обратитесь к менеджеру для уточнения деталей. -
5. Специальные требования
Для продукции, требующей особых условий (например, хранение при -80°C или в жидком азоте), предусмотрены индивидуальные решения. Наши специалисты помогут подобрать оптимальный вариант.
Для получения детальной информации, включая цену и сроки, обратитесь к менеджеру. Мы подберем для вас удобный и надежный способ получения товаров.
Документация
Гарантия
В интернет-магазине Молекулаб мы предоставляем гарантию на все наши товары. Вот некоторая информация о гарантии:
- 1. Длительность гарантии: Мы предоставляем гарантию на товары в течение определенного периода времени, который указан на странице товара или в документации к товару. Гарантийный срок на все приборы составляет 1 год, но может варьироваться в зависимости от конкретного товара до 3 лет.
- 2. Что покрывает гарантия: Гарантия покрывает дефекты в материалах и изготовлении товара, которые могут возникнуть в нормальных условиях использования. Если товар не соответствует заявленным характеристикам или имеет дефекты, мы обязуемся заменить или отремонтировать его в рамках гарантийных условий.
- 3. Исключения из гарантии: Гарантия не распространяется на повреждения, вызванные неправильной эксплуатацией, неправильным использованием или хранением товара, а также на повреждения, вызванные стихийными бедствиями или внешними факторами.
- 4. Процедура гарантийного обслуживания: Если у вас возникли проблемы с товаром в рамках гарантийного срока, пожалуйста, свяжитесь с нашей службой поддержки клиентов. Мы предоставим вам инструкции по возврату или ремонту товара в соответствии с гарантийными условиями.
Мы стремимся обеспечить высокое качество наших товаров и предоставить надежную гарантию на все приобретенные товары. Если у вас возникли вопросы или вам требуется дополнительная информация о гарантии, пожалуйста, обратитесь к нашей службе поддержки клиентов. Мы готовы помочь вам и обеспечить ваше удовлетворение от покупок в интернет-магазине Молекулаб.